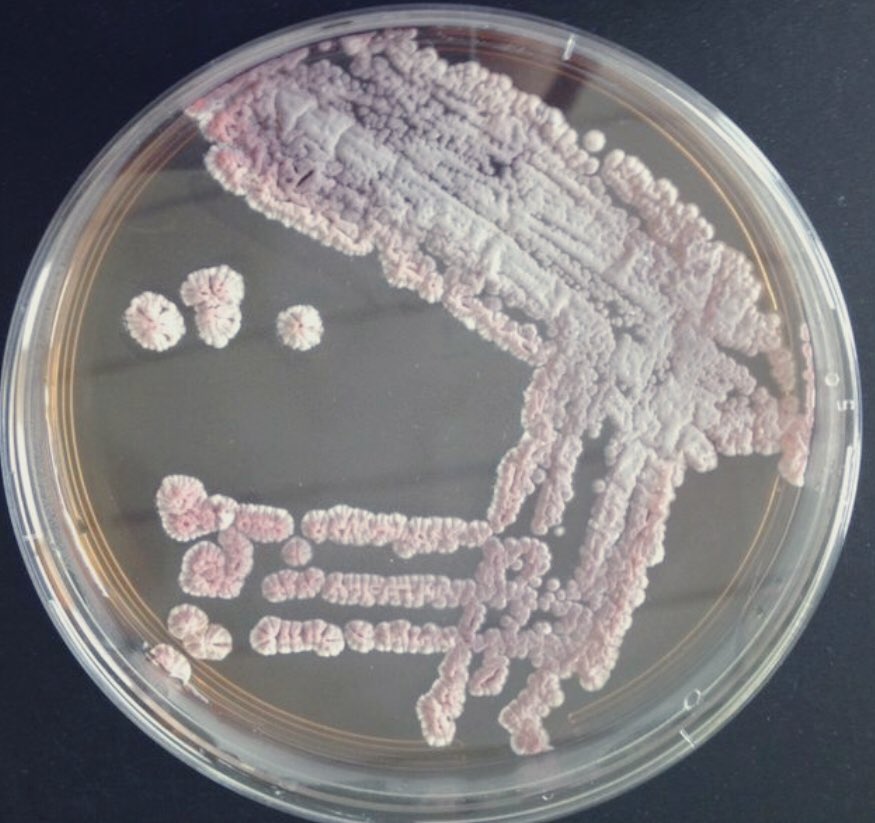

Актиномицеты среда
Расписание кинотеатра карнавал екатеринбург на сегодня
Математика 6 класс виленкин номер 1415
Автобус зеленоград соколово
Зарубежные музыкальные каналы
Танк арена батл мод
Туристические автобусы астрахань
Здание главного штаба в каком стиле
Новый свет фотографии
Блок электронный плавного пуска
Отдыха кубанец лермонтово
Список автомобилей ваз
Ббжм тест 4 класс
Ввгу абитуриента
Актиномицеты среда 107 фотографий